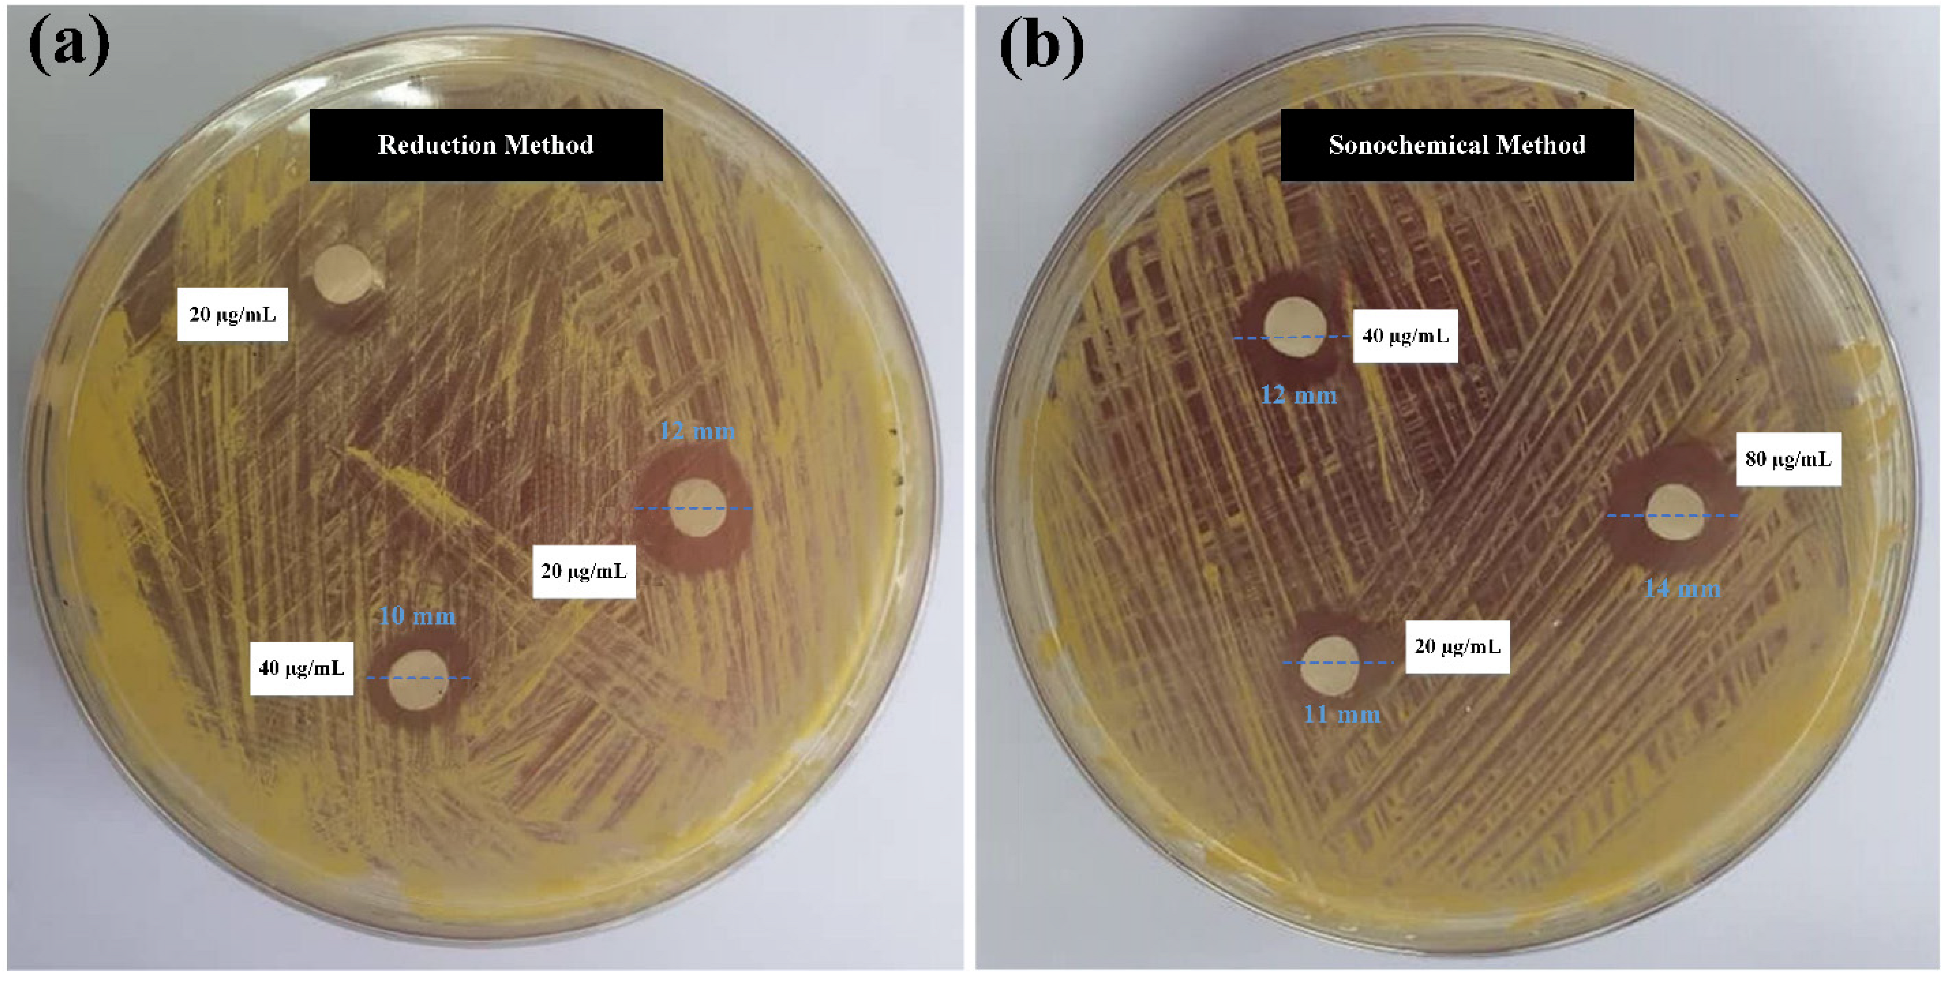

Comparative Analysis of Stable Gold Nanoparticles Synthesized Using Sonochemical and Reduction Methods for Antibacterial Activity
Abstract
1. Introduction
2. Results and Discussion
2.1. Physicochemical Characterizations
2.2. Antibacterial Activity of Gold NPs
2.3. Mechanisms of Action
3. Materials and Methods
3.1. Materials
3.2. Characterization of Au NPs
3.3. Ultrasonic Synthesis of Gold NPs
3.4. Conventional (Reduction) Synthesis of Gold NPs
3.5. Antibacterial Performance Assays
4. Conclusions
Author Contributions
Funding
Institutional Review Board Statement
Informed Consent Statement
Data Availability Statement
Acknowledgments
Conflicts of Interest
References
- Narayanan, K.B.; Sakthivel, N. Green synthesis of biogenic metal nanoparticles by terrestrial and aquatic phototrophic and heterotrophic eukaryotes and biocompatible agents. Adv. Colloid Interface Sci. 2011, 169, 59–79. [Google Scholar] [CrossRef] [PubMed]
- Abid, N.; Abid, N.; Khan, A.M.; Shujait, S.; Chaudhary, K.; Ikram, M.; Imran, M. Synthesis of nanomaterials using various top-down and bottom-up approaches, influencing factors, advantages, and disadvantages: A review. Adv. Colloid Interface Sci. 2022, 300, 102597. [Google Scholar] [CrossRef] [PubMed]
- Dheyab, M.A.; Dheyab, M.A.; Aziz, A.A.; Jameel, M.S.; Oladzadabbasabadi, N. Recent advances in synthesis, modification, and potential application of tin oxide nanoparticles. Surf. Interfaces 2022, 28, 101677. [Google Scholar] [CrossRef]
- Dheyab, M.A.; Dheyab, M.A.; Aziz, A.A.; Jameel, M.S.; Noqta, O.A.; Khaniabadi, P.M.; Mehrdel, B. Excellent relaxivity and X-ray attenuation combo properties of Fe3O4@ Au CSNPs produced via Rapid sonochemical synthesis for MRI and CT imaging. Mater. Today Commun. 2020, 25, 101368. [Google Scholar] [CrossRef]
- Jameel, M.S.; Aziz, A.A.; Dheyab, M.A. Impacts of various solvents in ultrasonic irradiation and green synthesis of platinum nanoparticle. Inorg. Chem. Commun. 2021, 128, 108565. [Google Scholar] [CrossRef]
- Dheyab, M.A.; Aziz, A.A.; Jameel, M.S. Synthesis and optimization of the sonochemical method for functionalizing gold shell on Fe3O4 core nanoparticles using response surface methodology. Surf. Interfaces 2020, 21, 100647. [Google Scholar] [CrossRef]
- Khaniabadi, P.M.; Shahbazi-Gahrouei, D.; Aziz, A.A.; Dheyab, M.A.; Khaniabadi, B.M.; Mehrdel, B. Trastuzumab conjugated porphyrin-superparamagnetic iron oxide nanoparticle: A potential PTT-MRI bimodal agent for herceptin positive breast cancer. Photodiagn. Photodyn. Ther. 2020, 31, 101896. [Google Scholar] [CrossRef] [PubMed]
- Dheyab, M.A.; Aziz, A.A.; Khaniabadi, P.M.; Jameel, M.S. Potential of a sonochemical approach to generate MRI-PPT theranostic agents for breast cancer. Photodiagn. Photodyn. Ther. 2021, 33, 102177. [Google Scholar] [CrossRef]
- Jameel, M.S.; Aziz, A.A.; Dheyab, M.A.; Mehrdel, B. Rapid methanol-assisted amalgamation of high purity platinum nanoparticles utilizing sonochemical strategy and investigation on its catalytic activity. Surf. Interfaces 2020, 21, 100785. [Google Scholar] [CrossRef]
- Braim, F.S.; Ab Razak, N.N.A.N.; Aziz, A.A.; Dheyab, M.A.; Ismael, L.Q. Optimization of ultrasonic-assisted approach for synthesizing a highly stable biocompatible bismuth-coated iron oxide nanoparticles using a face-centered central composite design. Ultrason. Sonochem. 2023, 95, 106371. [Google Scholar] [CrossRef]
- Rabeea, M.A.; Owaid, M.N.; Aziz, A.A.; Jameel, M.S.; Dheyab, M.A. Mycosynthesis of gold nanoparticles using the extract of Flammulina velutipes, Physalacriaceae, and their efficacy for decolorization of methylene blue. J. Environ. Chem. Eng. 2020, 8, 103841. [Google Scholar] [CrossRef]
- Owaid, M.N.; Rabeea, M.A.; Aziz, A.A.; Jameel, M.S.; Dheyab, M.A. Mushroom-assisted synthesis of triangle gold nanoparticles using the aqueous extract of fresh Lentinula edodes (shiitake), Omphalotaceae. Environ. Nanotechnol. Monit. Manag. 2019, 12, 100270. [Google Scholar] [CrossRef]
- Owaid, M.N.; Rabeea, M.A.; Aziz, A.A.; Jameel, M.S.; Dheyab, M.A. Mycogenic fabrication of silver nanoparticles using Picoa, Pezizales, characterization and their antifungal activity. Environ. Nanotechnol. Monit. Manag. 2022, 17, 100612. [Google Scholar] [CrossRef]
- Ramazanli, V.; Ahmadov, I. Synthesis of silver nanoparticles by using extract of olive leaves. Adv. Biol. Earth Sci. 2022, 7, 238–244. [Google Scholar]
- Guo, W.; Gao, W.; Li, Q.; Qu, S.; Zhang, L.; Tan, L.-L. Plasmon-enhanced visible-light photocatalytic antibacterial activity of metal-organic framework/gold nanocomposites. J. Mater. Chem. A 2023, 11, 2391–2401. [Google Scholar] [CrossRef]
- Huang, X.; Huang, X.; Jain, P.K.; El-Sayed, I.H.; El-Sayed, M.A. Gold nanoparticles: Interesting optical properties and recent applications in cancer diagnostics and therapy. Nanomedicine 2007, 2, 681. [Google Scholar] [CrossRef]
- Shamaila, S.; Zafar, N.; Riaz, S.; Sharif, R.; Nazir, J.; Naseem, S. Gold nanoparticles: An efficient antimicrobial agent against enteric bacterial human pathogen. Nanomaterials 2016, 6, 71. [Google Scholar] [CrossRef]
- Wang, L.; Li, S.; Yin, J.; Yang, J.; Li, Q.; Zheng, W. The density of surface coating can contribute to different antibacterial activities of gold nanoparticles. Nano Lett. 2020, 20, 5036–5042. [Google Scholar] [CrossRef]
- Dheyab, M.A.; Owaid, M.N.; Rabeea, M.A.; Aziz, A.A.; Jameel, M.S. Mycosynthesis of gold nanoparticles by the Portabello mushroom extract, Agaricaceae, and their efficacy for decolorization of Azo dye. Environ. Nanotechnol. Monit. Manag. 2020, 14, 100312. [Google Scholar] [CrossRef]
- Karthiga, P.; Rajeshkumar, S.; Annadurai, G. Mechanism of larvicidal activity of antimicrobial silver nanoparticles synthesized using Garcinia mangostana bark extract. J. Clust. Sci. 2018, 29, 1233–1241. [Google Scholar] [CrossRef]
- Tran, T.T.T.; Vu, T.T.H.; Nguyen, T.H. Biosynthesis of silver nanoparticles using Tithonia diversifolia leaf extract and their antimicrobial activity. Mater. Lett. 2013, 105, 220–223. [Google Scholar] [CrossRef]
- Lok, C.-N.; Ho, C.-M.; Chen, R.; He, Q.-Y.; Yu, W.-Y.; Sun, H. Silver nanoparticles: Partial oxidation and antibacterial activities. JBIC J. Biol. Inorg. Chem. 2007, 12, 527–534. [Google Scholar] [CrossRef] [PubMed]
- Arenas-Salinas, M.; Vargas-Pérez, J.I.; Morales, W.; Pinto, C.; Muñoz-Díaz, P.; Cornejo, F.A. Flavoprotein-mediated tellurite reduction: Structural basis and applications to the synthesis of tellurium-containing nanostructures. Front. Microbiol. 2016, 7, 1160. [Google Scholar] [CrossRef] [PubMed]
- Jameel, M.S.; Aziz, A.A.; Dheyab, M.A.; Khaniabadi, P.M.; Kareem, A.A.; Alrosan, M. Mycosynthesis of ultrasonically-assisted uniform cubic silver nanoparticles by isolated phenols from Agaricus bisporus and its antibacterial activity. Surf. Interfaces 2022, 29, 101774. [Google Scholar] [CrossRef]
- Dheyab, M.A.; Aziz, A.A.; Moradi Khaniabadi, P.; Jameel, M.S.; Oladzadabbasabadi, N.; Mohammed, S.A. Monodisperse gold nanoparticles: A review on synthesis and their application in modern medicine. Int. J. Mol. Sci. 2022, 23, 7400. [Google Scholar] [CrossRef]
- Dheyab, M.A.; Aziz, A.A.; Jameel, M.S.; Khaniabadi, P.M.; Mehrdel, B. Sonochemical-assisted synthesis of highly stable gold nanoparticles catalyst for decoloration of methylene blue dye. Inorg. Chem. Commun. 2021, 127, 108551. [Google Scholar] [CrossRef]
- Dheyab, M.A.; Abdul Aziz, A.; Jameel, M.S.; Moradi Khaniabadi, P.; Oglat, A.A. Rapid sonochemically-assisted synthesis of highly stable gold nanoparticles as computed tomography contrast agents. Appl. Sci. 2020, 10, 7020. [Google Scholar] [CrossRef]
- Braim, F.S.; Ab Razak, N.N.A.N.; Aziz, A.A.; Dheyab, M.A.; Ismael, L.Q. Rapid green-assisted synthesis and functionalization of superparamagnetic magnetite nanoparticles using Sumac extract and assessment of their cellular toxicity, uptake, and anti-metastasis property. Ceram. Int. 2023, 49, 7359–7369. [Google Scholar] [CrossRef]
- Teeguarden, J.G.; Hinderliter, P.M.; Orr, G.; Thrall, B.D.; Pounds, J.G. Particokinetics In Vitro: Dosimetry Considerations for In Vitro Nanoparticle Toxicity Assessments. Toxicol. Sci. 2007, 95, 300. [Google Scholar] [CrossRef]
- Shrivastava, S.; Bera, T.; Roy, A.; Singh, G.; Ramachandrarao, P.; Dash, D. Characterization of enhanced antibacterial effects of novel silver nanoparticles. Nanotechnology 2007, 18, 225103. [Google Scholar] [CrossRef]
- Hunter, R.J. Double layer interaction and particle coagulation. Found. Colloid Sci. 2001, 2, 635. [Google Scholar]
- Popa, I.; Gillies, G.; Papastavrou, G.; Borkovec, M. Attractive and repulsive electrostatic forces between positively charged latex particles in the presence of anionic linear polyelectrolytes. J. Phys. Chem. B 2010, 114, 3170–3177. [Google Scholar] [CrossRef] [PubMed]
- Mafuné, F.; Kohno J-y Takeda, Y.; Kondow, T.; Sawabe, H. Formation and size control of silver nanoparticles by laser ablation in aqueous solution. J. Phys. Chem. B 2000, 104, 9111–9117. [Google Scholar] [CrossRef]
- Yu, D.; Yam, V.W.-W. Hydrothermal-induced assembly of colloidal silver spheres into various nanoparticles on the basis of HTAB-modified silver mirror reaction. J. Phys. Chem. B 2005, 109, 5497–5503. [Google Scholar] [CrossRef] [PubMed]
- Dheyab, M.A.; Aziz, A.A.; Khaniabadi, P.M.; Jameel, M.S.; Ahmed, N.M.; Ali, A.T. Distinct advantages of using sonochemical over laser ablation methods for a rapid-high quality gold nanoparticles production. Mater. Res. Express 2021, 8, 015009. [Google Scholar] [CrossRef]
- Joshi, C.P.; Bigioni, T.P. Model for the phase transfer of nanoparticles using ionic surfactants. Langmuir 2014, 30, 13837–13843. [Google Scholar] [CrossRef]
- Rabeea, M.A.; Naeem, G.A.; Owaid, M.N.; Aziz, A.A.; Jameel, M.S.; Dheyab, M.A. Phytosynthesis of Prosopis farcta fruit-gold nanoparticles using infrared and thermal devices and their catalytic efficacy. Inorg. Chem. Commun. 2021, 133, 108931. [Google Scholar] [CrossRef]
- Mehrdel, B.; Othman, N.; Aziz, A.A.; Khaniabadi, P.M.; Jameel, M.S.; Dheyab, M.A. Identifying metal nanoparticle size effect on sensing common human plasma protein by counting the sensitivity of optical absorption spectra damping. Plasmonics 2020, 15, 123–133. [Google Scholar] [CrossRef]
- Zhou, H.; Lee, J.; Park, T.J.; Lee, S.J.; Park, J.Y.; Lee, J. Ultrasensitive DNA monitoring by Au–Fe3O4 nanocomplex. Sens. Actuators B Chem. 2012, 163, 224–232. [Google Scholar] [CrossRef]
- Link, S.; El-Sayed, M.A. Optical spectroscopy of surface plasmons in metal nanoparticles. In Semiconductor and Metal Nanocrystals; CRC Press: Boca Raton, FL, USA, 2003; pp. 415–444. [Google Scholar]
- Patra, J.K.; Baek, K.-H. Novel green synthesis of gold nanoparticles using Citrullus lanatus rind and investigation of proteasome inhibitory activity, antibacterial, and antioxidant potential. Int. J. Nanomed. 2015, 10, 7253. [Google Scholar]
- Khaniabadi, P.M.; Ahmed, N.M.; Dheyab, M.A.; Aziz, A.A.; Almessiere, M. Structure, morphology and absorption characteristics of gold nanoparticles produced via PLAL method: Role of low energy X-ray dosage. Surf. Interfaces 2021, 24, 101139. [Google Scholar] [CrossRef]
- Hao, H.; Wu, M.; Chen, Y.; Tang, J.; Wu, Q. Cavitation mechanism in cyanobacterial growth inhibition by ultrasonic irradiation. Colloids Surf. B Biointerfaces 2004, 33, 151–156. [Google Scholar] [CrossRef]
- Talebi, J.; Halladj, R.; Askari, S. Sonochemical synthesis of silver nanoparticles in Y-zeolite substrate. J. Mater. Sci. 2010, 45, 3318–3324. [Google Scholar] [CrossRef]
- Horisberger, M. Quantitative aspects of labelling colloidal gold with proteins in immunocytochemistry. In Trends in Colloid and Interface Science IV; Steinkopff: Heidelberg, Germany, 1990; pp. 156–160. [Google Scholar]
- Ghadimi, A.; Saidur, R.; Metselaar, H. A review of nanofluid stability properties and characterization in stationary conditions. Int. J. Heat Mass Transf. 2011, 54, 4051–4068. [Google Scholar] [CrossRef]
- Mahbubul, I.; Saidur, R.; Amalina, M.; Elcioglu, E.; Okutucu-Ozyurt, T. Effective ultrasonication process for better colloidal dispersion of nanofluid. Ultrason. Sonochem. 2015, 26, 361–369. [Google Scholar] [CrossRef]
- Suslick, K.S.; Didenko, Y.; Fang, M.M.; Hyeon, T.; Kolbeck, K.J.; McNamara, W.B., III. Acoustic cavitation and its chemical consequences. Philos. Trans. R. Soc. Lond. Ser. A Math. Phys. Eng. Sci. 1999, 357, 335–353. [Google Scholar] [CrossRef]
- Bang, J.H.; Suslick, K.S. Applications of ultrasound to the synthesis of nanostructured materials. Adv. Mater. 2010, 22, 1039–1059. [Google Scholar] [CrossRef]
- Wolloch, L.; Kost, J. The importance of microjet vs. shock wave formation in sonophoresis. J. Controlled Release 2010, 148, 204–211. [Google Scholar] [CrossRef]
- Jameel, M.S.; Aziz, A.A.; Dheyab, M.A. Comparative analysis of platinum nanoparticles synthesized using sonochemical-assisted and conventional green methods. Nano-Struct. Nano-Objects 2020, 23, 100484. [Google Scholar] [CrossRef]
- Kvítek, L.; Panáček, A.; Soukupova, J.; Kolář, M.; Večeřová, R.; Prucek, R. Effect of surfactants and polymers on stability and antibacterial activity of silver nanoparticles (NPs). J. Phys. Chem. C 2008, 112, 5825–5834. [Google Scholar] [CrossRef]
- Zhou, Y.; Kong, Y.; Kundu, S.; Cirillo, J.D.; Liang, H. Antibacterial activities of gold and silver nanoparticles against Escherichia coli and bacillus Calmette-Guérin. J. Nanobiotechnol. 2012, 10, 1–9. [Google Scholar] [CrossRef] [PubMed]
- Tillotson, G.S.; Theriault, N. New and alternative approaches to tackling antibiotic resistance. F1000prime Rep. 2013, 5, 51. [Google Scholar] [CrossRef] [PubMed]
- Badwaik, V.D.; Vangala, L.M.; Pender, D.S.; Willis, C.B.; Aguilar, Z.P.; Gonzalez, M.S. Size-dependent antimicrobial properties of sugar-encapsulated gold nanoparticles synthesized by a green method. Nanoscale Res. Lett. 2012, 7, 1–11. [Google Scholar] [CrossRef] [PubMed]
- Zheng, K.; Setyawati, M.I.; Leong, D.T.; Xie, J. Antimicrobial gold nanoclusters. ACS Nano 2017, 11, 6904–6910. [Google Scholar] [CrossRef]
- Rai, A.; Prabhune, A.; Perry, C.C. Antibiotic mediated synthesis of gold nanoparticles with potent antimicrobial activity and their application in antimicrobial coatings. J. Mater. Chem. 2010, 20, 6789–6798. [Google Scholar] [CrossRef]
- Ortiz-Benitez, E.A.; Carrillo-Morales, M.; Velázquez-Guadarrama, N.; Fandiño-Armas, J.; Olivares-Trejo, J.d.J. Inclusion bodies and pH lowering: As an effect of gold nanoparticles in Streptococcus pneumoniae. Metallomics 2015, 7, 1173–1179. [Google Scholar] [CrossRef]
- Zhang, L.W.; Monteiro-Riviere, N.A. Use of confocal microscopy for nanoparticle drug delivery through skin. J. Biomed. Opt. 2012, 18, 061214. [Google Scholar] [CrossRef]
- Mishra, A.; Mehdi, S.J.; Irshad, M.; Ali, A.; Sardar, M.; Moshahid, M. Effect of biologically synthesized silver nanoparticles on human cancer cells. Sci. Adv. Mater. 2012, 4, 1200–1206. [Google Scholar] [CrossRef]
- Jameel, M.S.; Aziz, A.A.; Dheyab, M.A.; Mehrdel, B.; Khaniabadi, P.M. Rapid sonochemically-assisted green synthesis of highly stable and biocompatible platinum nanoparticles. Surf. Interfaces 2020, 20, 100635. [Google Scholar] [CrossRef]

| Sample | hkl | 2Өo | D (nm) | Intensity (a.u) |
|---|---|---|---|---|
| (JCPDS card no. 01-089-3697 space group = Fm-3m) | 111 | 38.17 | 2.35 | 100% |
| 200 | 44.37 | 2.03 | 45.4 | |
| 220 | 64.56 | 1.44 | 23.9 | |
| 311 | 77.54 | 1.23 | 24.0 | |
| Gold NPs sonication | 111 | 38.18 | 2.35 | 100 |
| 200 | 44.41 | 2.03 | 24.42 | |
| 220 | 64.67 | 1.44 | 1.14 | |
| 311 | 77.8 | 1.22 | 2.29 | |
| Gold NPs conventional | 111 | 38.30 | 2.34 | 100 |
| 200 | 44.53 | 2.03 | 29.32 | |
| 220 | 64.87 | 1.43 | 2.32 | |
| 311 | 77.67 | 1.22 | 2.32 |
Disclaimer/Publisher’s Note: The statements, opinions and data contained in all publications are solely those of the individual author(s) and contributor(s) and not of MDPI and/or the editor(s). MDPI and/or the editor(s) disclaim responsibility for any injury to people or property resulting from any ideas, methods, instructions or products referred to in the content. |
© 2023 by the authors. Licensee MDPI, Basel, Switzerland. This article is an open access article distributed under the terms and conditions of the Creative Commons Attribution (CC BY) license (https://creativecommons.org/licenses/by/4.0/).
Share and Cite
Dheyab, M.A.; Aziz, A.A.; Oladzadabbasabadi, N.; Alsaedi, A.; Braim, F.S.; Jameel, M.S.; Ramizy, A.; Alrosan, M.; Almajwal, A.M. Comparative Analysis of Stable Gold Nanoparticles Synthesized Using Sonochemical and Reduction Methods for Antibacterial Activity. Molecules 2023, 28, 3931. https://doi.org/10.3390/molecules28093931
Dheyab MA, Aziz AA, Oladzadabbasabadi N, Alsaedi A, Braim FS, Jameel MS, Ramizy A, Alrosan M, Almajwal AM. Comparative Analysis of Stable Gold Nanoparticles Synthesized Using Sonochemical and Reduction Methods for Antibacterial Activity. Molecules. 2023; 28(9):3931. https://doi.org/10.3390/molecules28093931
Chicago/Turabian StyleDheyab, Mohammed Ali, Azlan Abdul Aziz, Nazila Oladzadabbasabadi, Alyaa Alsaedi, Farhank Saber Braim, Mahmood S. Jameel, Asmeit Ramizy, Mohammad Alrosan, and Ali Madi Almajwal. 2023. "Comparative Analysis of Stable Gold Nanoparticles Synthesized Using Sonochemical and Reduction Methods for Antibacterial Activity" Molecules 28, no. 9: 3931. https://doi.org/10.3390/molecules28093931
APA StyleDheyab, M. A., Aziz, A. A., Oladzadabbasabadi, N., Alsaedi, A., Braim, F. S., Jameel, M. S., Ramizy, A., Alrosan, M., & Almajwal, A. M. (2023). Comparative Analysis of Stable Gold Nanoparticles Synthesized Using Sonochemical and Reduction Methods for Antibacterial Activity. Molecules, 28(9), 3931. https://doi.org/10.3390/molecules28093931








